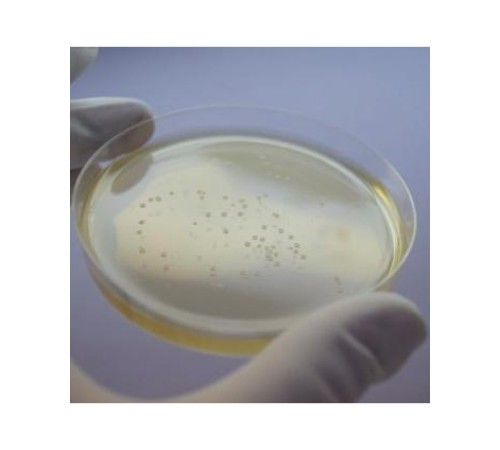

Не является лекарственным (фармацевтическим) препаратом. Не является БАД.
Не предназначен для проведения любых медицинских исследований или процедур.
Продажу химических реактивов осуществляем только юридическим лицам.
Используется для обнаружения и подсчета E.coli и колиформных бактерий стандартным методом и в экспресс-тестах.
Состав:
- Триптический гидролизат казеина сухой
- соевый пептон
- натрий углекислый
- агар бактериологический.Контроль качества:
тест-штамм | наблюдаемый эффект |
Escherichia coli АТСС 25922 Escherichia coli 3912/41 (О556:К59)Klebsiella pneumoniae 3534/51Citrobacter freundii 101/57Staphylococcus aureus ATCC 6538-PStreptococcus pyogenes Disk I | бесцветные круглые колонии диаметром 1,0 - 3,0 мм |
Нет отзывов об этом товаре.
Нет вопросов об этом товаре.
Доставка заказов осуществляется в любые регионы Российской Федерации и страны СНГ.
Цены на нашем сайте указаны с учетом НДС (20% либо 10%).
Оплата заказов производится только в безналичной форме на расчетный счет в рублях Российской Федерации на основании выставленного Счета.
Для бюджетных организаций и государственных структур предусмотрены особые условия оплаты.
Постоянным клиентам предоставляются скидки и индивидуальный порядок расчетов.
Внимание! В связи с нестабильным курсом валют и изменением цен у производителей, просим окончательную стоимость продукции уточнять у наших менеджеров.
Варианты доставки:
Самовывоз со склада в городе Клин
Адрес выдачи: Московская область, г. Клин, ул. Захватаева, д. 4, офис 101
Контактный телефон: +7 (977) 407-05-96
Доставка по Клину и Клинскому району – бесплатно
Доставка по Москве – 1 500 рублей
Доставка любыми транспортными компаниями, службами экспресс-доставки. Стоимость рассчитывается индивидуально для каждого заказа в соответствии с установленными тарифами транспортной компании. Все грузы застрахованы.
Компания "КомплектСнаб является официальным поставщиком от производителя ФБУН ГНЦ ПМБ Оболенск. Вы всегда можете получить бесплатную консультацию по продукции, получить КП и задать вопросы по подбору аналогов продукции.